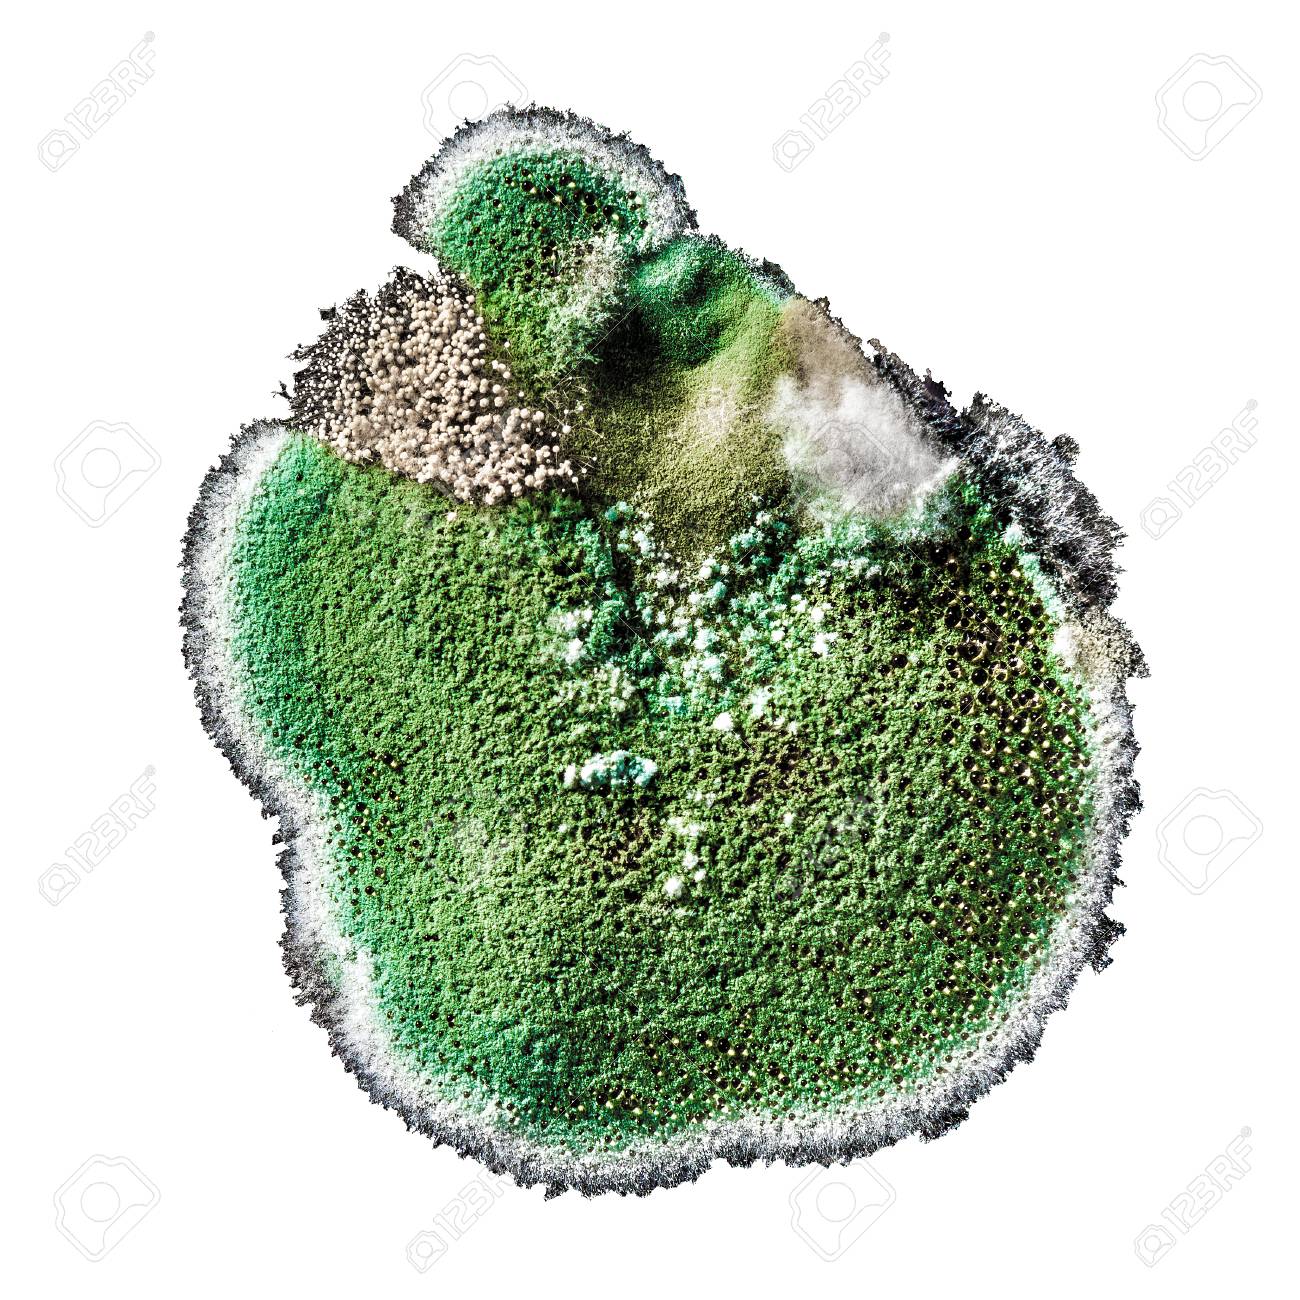
mofo verde em móveis

Você já abriu um pão e viu aqueles pontinhos verdes? Ou notou manchas esverdeadas na parede do banheiro? Pois é, o mofo verde é mais comum do que você imagina e pode ser um sinal de alerta para a sua saúde. Muita gente acha que é só raspar e pronto, mas a verdade é que o perigo pode estar bem mais profundo.
Seja em alimentos ou em casa, esse fungo não é apenas inestético: ele libera esporos que podem causar alergias, irritações e até problemas respiratórios sérios. A boa notícia é que com as técnicas certas você pode eliminar e prevenir o mofo verde de vez. Vamos direto ao que realmente funciona.
Afinal, o que é o mofo verde e por que ele aparece?
O mofo verde não é um bicho de sete cabeças, mas tem suas preferências. Ele adora umidade acima de 60%, pouca ventilação e cantos escuros. Os principais culpados são os fungos dos gêneros Aspergillus, Penicillium e Cladosporium – cada um com suas manias. O Aspergillus, por exemplo, é comum em paredes e alimentos secos como grãos; já o Penicillium adora frutas cítricas e queijos.
Na prática, se você tem infiltrações, condensação nas janelas ou acúmulo de poeira, as chances de ver mofo verde aumentam. Em móveis estofados e carpetes, a combinação de sujeira e umidade é um prato cheio. E não pense que só aparece no inverno: no verão, o calor úmido também favorece a proliferação.
O grande problema é que os esporos viajam pelo ar e podem desencadear reações alérgicas em até 30% das pessoas, segundo a Organização Mundial da Saúde. Tosse, espirros, olhos lacrimejando e irritação na garganta são os sinais mais comuns. Em quem já tem asma ou bronquite, o mofo verde pode ser um gatilho para crises severas.
O Invasor Esverdeado: Desvendando o Mofo Verde em Nossos Lares

Aquele toque de verde que aparece em casa, seja no pão esquecido na bancada ou naquela parede que parece suar, é um sinal claro: o mofo verde chegou. Mais do que uma questão estética, ele representa um alerta de saúde e um desafio para a manutenção do nosso lar. Compreender suas origens, os perigos que ele esconde e como combatê-lo é o primeiro passo para um ambiente mais seguro e saudável.
Essa proliferação fúngica, que adora umidade, escuridão e pouca circulação de ar, não escolhe lugar para se instalar. De alimentos a móveis, passando por cantinhos úmidos da casa, o mofo verde encontra um paraíso para se espalhar, liberando esporos que podem afetar nossa respiração e bem-estar. Vamos mergulhar fundo nesse universo para, finalmente, vencer essa batalha.
| Ambiente | Gêneros Comuns | Riscos | Soluções |
| Alimentos | Aspergillus, Penicillium | Toxinas, Alergias, Intoxicação | Descarte imediato, Não consumir |
| Paredes/Móveis/Carpetes | Aspergillus, Penicillium, Cladosporium | Alergias, Problemas Respiratórios, Deterioração | Limpeza com água sanitária diluída, Vinagre, Bicarbonato; Ventilação; Desumidificação |
Mofo Verde em Alimentos: Identificação e Riscos
A presença de mofo verde em alimentos é um sinal inequívoco de que o produto não está mais seguro para consumo. Geralmente associado a gêneros como Aspergillus e Penicillium, esse fungo não se limita à superfície visível. Suas raízes, chamadas de micélios, penetram profundamente no alimento, e com elas vêm as micotoxinas, substâncias perigosas que podem causar desde desconfortos gastrointestinais até problemas mais graves a longo prazo.
Leia também: Como limpar azulejo de banheiro em 30 minutos com produtos que você tem em casa
É um erro comum pensar que basta remover a parte mofada e consumir o restante. A verdade é que os esporos e as toxinas já se disseminaram por todo o alimento, mesmo onde não há visibilidade do mofo. Portanto, a regra de ouro é clara: ao notar qualquer sinal de mofo verde em alimentos, o descarte imediato é a única opção segura para evitar riscos à saúde.
Mofo Verde em Paredes: Causas e Soluções

O mofo verde em paredes é um dos problemas mais persistentes e visíveis, indicando quase sempre um desequilíbrio de umidade no ambiente. Infiltrações, vazamentos, condensação excessiva em banheiros e cozinhas, ou simplesmente a falta de ventilação adequada criam o cenário perfeito para sua proliferação. A umidade acumulada nas alvenarias serve de substrato ideal para os esporos de fungos como o Cladosporium encontrarem um lar.
A solução para o mofo verde em paredes passa por duas frentes: a eliminação do mofo existente e a correção da causa raiz. Uma limpeza inicial pode ser feita com soluções como água sanitária diluída (1 parte de água sanitária para 10 de água) ou uma pasta de bicarbonato de sódio com água. No entanto, sem resolver o problema da umidade – seja consertando vazamentos, melhorando a ventilação com janelas abertas ou usando um desumidificador –, o mofo verde voltará a aparecer, comprometendo a estrutura e a saúde do lar.
Mofo Verde em Móveis: Como Remover
Móveis, especialmente os de madeira ou estofados, são alvos frequentes do mofo verde, principalmente em locais com pouca circulação de ar e alta umidade, como armários embutidos ou cômodos pouco usados. A textura porosa desses materiais facilita a aderência e o crescimento dos fungos, podendo causar manchas permanentes e odores desagradáveis.
Leia também: 63 Ideias de 2 Quarto Plantas de Casas Pequenas para 2026
Para remover o mofo verde de móveis, a abordagem deve ser cuidadosa. Em superfícies de madeira não envernizada ou pintada, uma solução de vinagre branco pode ser eficaz. Para móveis estofados, um pano levemente umedecido com uma solução de água e sabão neutro, seguido de secagem completa com um ventilador, pode ajudar. O uso de um aspirador com filtro HEPA após a limpeza também é recomendado para capturar esporos soltos. A chave é garantir que o móvel seque completamente para evitar a recorrência.
Tipos de Mofo Verde: Aspergillus, Penicillium e Cladosporium
O termo ‘mofo verde’ engloba diversos gêneros de fungos, cada um com suas particularidades. O Aspergillus é um dos mais conhecidos, frequentemente encontrado em alimentos e também em ambientes úmidos de casas, podendo ter colorações variadas, incluindo o verde. O Penicillium, famoso por sua associação com queijos e pães, também pode aparecer em frutas cítricas e milho, manifestando-se com tons esverdeados característicos.
Já o Cladosporium, que geralmente exibe uma tonalidade verde-oliva, é comum em tecidos, madeiras e até mesmo em superfícies pintadas de casas com problemas de umidade e ventilação. A identificação exata do gênero pode ser complexa sem análise laboratorial, mas o importante é reconhecer que todos esses tipos de mofo verde compartilham a necessidade de umidade para prosperar e podem apresentar riscos à saúde.
Riscos do Mofo Verde à Saúde
A exposição aos esporos do mofo verde pode desencadear uma série de reações alérgicas em pessoas sensíveis. Sintomas como tosse persistente, espirros frequentes, coriza, lacrimejamento nos olhos e irritação na garganta são comuns. Para indivíduos que já sofrem de condições respiratórias, como asma, bronquite ou sinusite, o mofo verde pode atuar como um gatilho, agravando significativamente os quadros e diminuindo a qualidade de vida.
Em casos mais extremos, especialmente em pessoas com o sistema imunológico comprometido, a inalação de esporos pode levar a infecções fúngicas mais sérias, conhecidas como micoses invasivas. A ingestão de alimentos contaminados com mofo verde e suas toxinas representa um risco adicional, podendo causar intoxicações agudas ou problemas crônicos de saúde. A conscientização sobre esses riscos é fundamental para motivar ações de limpeza e prevenção.
Como Eliminar Mofo Verde Passo a Passo
Preparação é fundamental: Antes de iniciar a limpeza, certifique-se de usar equipamentos de proteção individual. Luvas de borracha e uma máscara contra poeira (idealmente PFF2 ou N95) são indispensáveis para evitar o contato com os esporos e as soluções de limpeza. Abra as janelas para garantir a ventilação do ambiente durante todo o processo.
Escolha a solução certa: Para superfícies não porosas como azulejos e paredes pintadas, uma solução de água sanitária diluída (1 parte de água sanitária para 10 de água) é eficaz. Para áreas mais sensíveis ou onde a água sanitária não é recomendada, vinagre branco puro ou uma pasta de bicarbonato de sódio com água podem ser alternativas. Teste sempre em uma área pequena e discreta antes de aplicar em toda a superfície.
Aplicação e remoção: Aplique a solução escolhida sobre a área mofada, deixando agir por alguns minutos. Esfregue suavemente com uma escova ou esponja para remover o mofo. Enxágue a área com um pano limpo e úmido e, em seguida, seque completamente com um pano seco ou ventilador. A secagem total é crucial para impedir o retorno do mofo verde.
Prevenção de Mofo Verde em Casa
A melhor forma de lidar com o mofo verde é, sem dúvida, evitar que ele apareça. A prevenção se baseia em controlar a umidade e garantir uma boa circulação de ar em todos os ambientes da casa. Isso significa consertar imediatamente qualquer vazamento ou infiltração em telhados, paredes ou tubulações, pois são as principais portas de entrada para a umidade excessiva.
Manter os ambientes ventilados é outra medida essencial. Abra janelas e portas diariamente, especialmente em banheiros após o banho e cozinhas durante o preparo de alimentos. Em locais com alta umidade e pouca ventilação natural, como armários e cômodos fechados, o uso de desumidificadores pode ser um investimento valioso. A limpeza regular, mantendo superfícies secas, também impede que os esporos encontrem condições favoráveis para se desenvolver.
2026: A Luta Contra o Mofo Verde Ganha Novos Aliados
Em 2026, a conscientização sobre os impactos do mofo verde na saúde e na estrutura das edificações atingiu um novo patamar. A busca por soluções não se limita mais à simples remoção, mas foca em abordagens mais sustentáveis e eficazes para controle de umidade e qualidade do ar interior. A tecnologia de materiais de construção, por exemplo, avança com revestimentos e tintas que inibem o crescimento de fungos, e a popularização de sistemas de ventilação mecânica controlada (VMC) em residências brasileiras começa a mudar o cenário.
O desafio continua, mas as ferramentas e o conhecimento para combatê-lo estão cada vez mais acessíveis. A combinação de boas práticas de manutenção, atenção à ventilação e o uso inteligente de tecnologias de controle de umidade são o caminho para garantir lares livres do mofo verde e mais saudáveis para todos. A prevenção, como sempre, é o melhor remédio.
Leia também: 47 Ideias de Tijolinho a Vista para Você se Inspirar
O Mofo Verde Exige um Protocolo
Antes de tudo, identifique a extensão do problema. Manchas superficiais em azulejos ou rejunte podem ser tratadas com vinagre branco puro, mas infiltrações em paredes de gesso exigem intervenção mais profunda.
Para remoção em superfícies laváveis, use água sanitária diluída (1:10). Aplique com borrifador, deixe agir por 15 minutos e esfregue com escova macia, sempre usando luvas e máscara N95.
Em móveis estofados e carpetes, o vinagre é mais seguro. Borrife uma solução 1:1 com água, seque com pano limpo e exponha ao sol por pelo menos 2 horas para eliminar esporos.
Nunca varra ou aspire mofo seco. Isso dispersa esporos no ar, agravando alergias. Use aspirador com filtro HEPA ou umedeça a superfície antes da limpeza.
Após a remoção, corrija a causa raiz. Instale um desumidificador em áreas com umidade acima de 60% e vede trincas e infiltrações para evitar reincidência.
Em casos de mofo em alimentos, descarte imediatamente. As toxinas podem se espalhar além da parte visível, mesmo em queijos duros. Nunca tente ‘salvar’ a parte boa.
Perguntas Frequentes Sobre Mofo Verde
O mofo verde é mais perigoso que o mofo preto? Não necessariamente. Embora o mofo preto (Stachybotrys) produza micotoxinas potentes, o mofo verde (Aspergillus, Penicillium) também causa alergias e infecções, principalmente em imunocomprometidos.
Posso pintar por cima do mofo verde? Não. A tinta não mata o fungo; apenas o esconde temporariamente. O mofo continuará crescendo por baixo, danificando a parede e liberando esporos. Remova completamente antes de pintar.
Desumidificador resolve o problema de mofo? Ajuda a prevenir, mas não elimina o mofo já existente. Use-o para manter a umidade abaixo de 50% após a limpeza completa da área afetada.
O mofo verde não é apenas um incômodo estético; é um risco real à saúde respiratória. Com as técnicas certas de remoção e prevenção, você pode transformar ambientes insalubres em espaços seguros e saudáveis.
Comece hoje mesmo inspecionando cantos úmidos e aplicando o protocolo de limpeza com vinagre ou água sanitária. Invista em um desumidificador e na vedação de infiltrações para garantir que o mofo não volte.
Em 2026, a tendência é que soluções sustentáveis, como tintas antimofo e sistemas de ventilação inteligentes, dominem o mercado. Mantenha-se informado e proteja sua casa com consciência e estilo.


